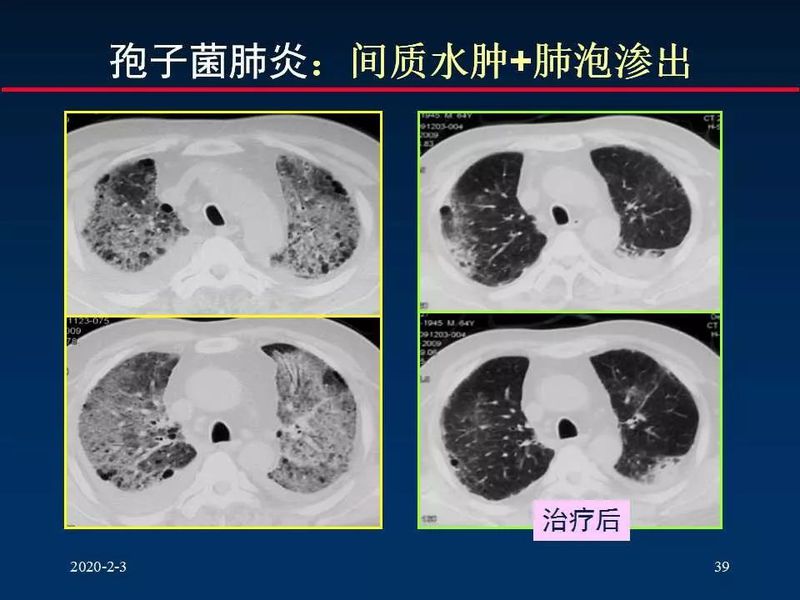
图片

肺间质是指肺的纤维结缔组织构成的框架结构,包括:各级支气管和血管周围、小叶间隔、胸膜下和沿肺泡壁分布的纤维结缔组织。
肺间质分为三部分:
中轴纤维系统:支气管血管周围间质和小叶中心间质
周围纤维系统:胸膜下间质和小叶间隔
间隔纤维间质:小叶内间质






1、胸膜下线 subpleural lines
2、支气管血管周围间质增厚 Peribronchoascular interstitial thinckening
3、网格状改变 reticular opacity (小叶间隔增厚)
4、细网格状改变 Fine reticular opacity (小叶内间质增厚)
5、蜂窝状改变 Honeycombing opacity
6、磨玻璃密度 ground glass density

肺间质的解剖及其基本病理改变是CT征象的基础;
准确掌握不同解剖位置间质改变的CT特征有助于对不同疾病进行精确分析与鉴别。
肺炎和间质性肺炎是两种不同的肺部疾病,它们的主要区别在于病因、病理表现、以及临床症状。
病因不同
肺炎主要由细菌、病毒或其他微生物感染引起,如肺炎链球菌、流感病毒等。
间质性肺炎则更多是由于环境因素、药物、结缔组织疾病(如类风湿关节炎)、或原因不明的“特发性”因素引起。它并非由直接感染导致,而是与肺间质的炎症和纤维化改变有关。
病理表现不同
实质的炎症,涉及终末气道、肺泡,通常伴有肺间质的炎症。
间质性肺炎则主要表现为肺间质的炎症性改变,尤其是肺间质腔的扩大和炎症细胞浸润,可能伴有纤维化。
临床症状不同
肺炎常见的症状包括发热、咳嗽、咳痰、呼吸困难等,症状通常出现较急,且可能伴有全身症状如寒战、乏力等。
间质性肺炎的症状则通常隐匿出现,表现为逐渐加重的呼吸困难,有时伴有刺激性干咳,症状通常不伴有发热,这可能导致患者和医生忽视其严重性。
诊断和治疗
肺炎的诊断主要通过临床症状、体检和实验室检查(如血液检查、影像学检查),治疗主要针对感染病原体,使用抗生素或其他药物。
间质性肺炎的诊断较为复杂,可能需要更高的分辨率的影像学检查如高分辨CT,治疗则更侧重于症状缓解和疾病进展的延缓,可能包括使用糖皮质激素和其他抗纤维化药物。
总之,肺炎和间质性肺炎在病因、病理、临床症状及治疗方法上都有明显的区别。正确的诊断和区分对于采取适当的治疗措施至关重要。
来源:华夏影像诊断中心
